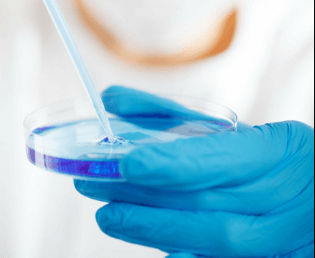

States Add Coverage Mandates to Cover Infertility Treatment following Cancer Treatments
Under the Affordable Care Act (ACA), individual and small group plans must cover essential health benefits, such as pre-existing conditions. However, states can go beyond the ACA’s requirements and mandate coverage for other conditions, such as infertility or autism, though they must cover those additional costs.
A new wave of state mandates have expanded what insurers must cover in the area of infertility treatment. Since 2017, 15 states have introduced legislation that would mandate coverage of fertility preservation – which includes the removal and storage of eggs and sperm – prior to radiation and chemotherapy treatment for cancer. Five states – Connecticut, Rhode Island, Maryland, Delaware, and Illinois — have enacted this legislation, and New Jersey has a bill pending.
According to the Oncofertility Consortium, a multi-institutional and disciplinary organization focused on advancing the understanding of the impact of cancer treatment on the reproductive health of patients, more than 150,000 people age 45 and younger in the United States will be diagnosed with cancer. Most of these patients face excellent prospects for survival, but that survival will also carry consequences. One of the long-term side effects of many cancer treatments is infertility. Patients undergoing some surgeries — having radiation to particular parts of their body or receiving specific types of chemotherapy — may suffer damage to their reproductive system that makes it difficult, or in some cases, impossible, to have children after treatment. As a result, these consumers have increasingly looked to fertility preservation.
Fertility preservation is a process that allows patients to remove and store reproductive cells – eggs and sperm – from their body, before undergoing potentially sterilizing medical treatments. Over the past decade, reproductive technologies have evolved, creating new and more efficient options for fertility preservation. Much of this work has been driven by organizations like the Oncofertility Consortium, a multi-institutional, multi-disciplinary organization focused on advancing the understanding of the impact of cancer treatment on the reproductive health of patients.
Currently, standard techniques for fertility preservation include sperm banking for men and egg or embryo freezing for women. Emerging techniques such as ovarian and testicular tissue banking allow prepubertal patients, who do not have mature eggs or sperm, to preserve their possibility for genetic children in the future.
Despite guidelines from the American Society of Clinical Oncology (ASCO) identifying oncology providers’ responsibility to inform all eligible patients about the reproductive risks and options for mitigating these risks, studies continue to show that patients don’t always understand their risks or feel adequately informed about their options. One factor in keeping fertility preservation use low is the high cost of services, particularly for women. Sperm banking can cost several hundred dollars; egg or embryo freezing often exceeds $10,000.00. For patients who are newly diagnosed with cancer who must access these services immediately, these costs, which are typically not covered by insurance, are often insurmountable.
While bills mandating this insurance coverage have differed slightly, generally they provide coverage for standard fertility preservation procedures as recognized by the American Society for Reproductive Medicine (ASRM) and/or ASCO, and anyone (not just cancer patients) facing “iatrogenic infertility” — infertility caused by a necessary medical intervention. They do not include:
- Coverage for “elective” fertility preservation, such as egg freezing sought due to natural aging;
- Coverage for infertility treatments such as in vitro fertilization that might be needed after cancer treatment to achieve a pregnancy, only for the preservation of the eggs/sperm; or
- Long-term storage costs.
Several states are expected to either introduce or reintroduce fertility preservation coverage bills in 2019. On the federal level, in May the Access to Infertility Treatment and Care Act (H.R. 5965 and S. 2920), was introduced. This bill would require health plans in group and individual markets to cover treatments for the infertility. It would also require coverage of fertility preservation services for patients undergoing medically-necessary procedures that may result in infertility.

For individuals living with complex, often chronic conditions, and their families, palliative care can provide relief from symptoms, improve satisfaction and outcomes, and help address critical mental and spiritual needs during difficult times. Now more than ever, there is growing recognition of the importance of palliative care services for individuals with serious illness, such as advance care planning, pain and symptom management, care coordination, and team-based, multi-disciplinary support. These services can help patients and families cope with the symptoms and stressors of disease, better anticipate and avoid crises, and reduce unnecessary and/or unwanted care. While this model is grounded in evidence that demonstrates improved quality of life, better outcomes, and reduced cost for patients, only a fraction of individuals who could benefit from palliative care receive it. 























































































































































